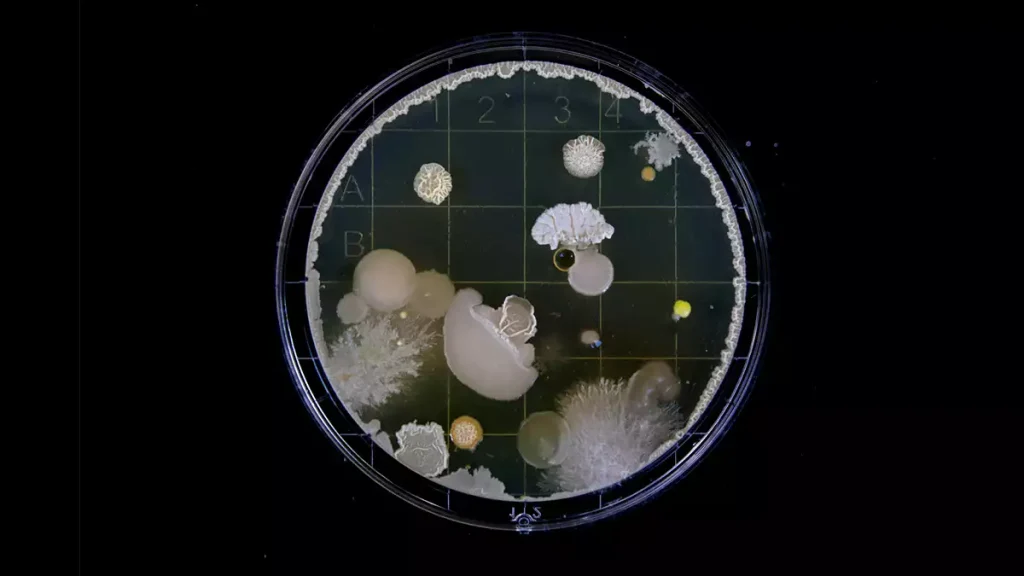
باکتری کش های گیاهی

بیماری آنتراکنوز در گیاهان، علائم، علل و روش های کنترل
بیماری آنتراکنوز (Anthracnose) یکی از بیماری های شایع در گیاهان است که توسط گروهی از قارچ ها ایجاد میشود. این بیماری معمولاً به شکل لکه های تیره یا قهوه ای بر روی برگ ها، ساقه ها و میوه های گیاهان ظاهر میشود و می تواند به سرعت گسترش یابد. آنتراکنوز یکی از مشکلات جدی در کشاورزی است و می تواند باعث کاهش عملکرد و کیفیت محصولات کشاورزی شود.
تعریف و علائم بیماری آنتراکنوز
آنتراکنوز به مجموعهای از بیماریها اطلاق میشود که بهوسیله قارچ های مختلف از جنس های Colletotrichum، Gloeosporium و Glomerella ایجاد می شود. این قارچها به بخشهای مختلف گیاه مانند برگ، ساقه، میوه و گل حمله کرده و در نهایت باعث آسیبهای جدی به گیاه میشوند.
علائم اصلی بیماری آنتراکنوز
-
لکه های تیره یا قهوه ای روی برگ ها: این لکه ها معمولاً گرد یا بیضی شکل هستند و ممکن است به تدریج گسترش یابند.
-
پوسیدگی میوه ها: میوه های آلوده به آنتراکنوز ابتدا لکه های قهوه ای به صورت حفرهای می گیرند که باعث کاهش کیفیت میوه میشود.
-
زخم ها روی ساقه ها: در برخی گیاهان، زخم هایی روی ساقه ها مشاهده میشود که ممکن است بهصورت ترک ها یا لکه های قهوه ای نمایان شوند.
-
مرگ بافت ها و خشک شدن گیاه: در مراحل پیشرفته، بیماری می تواند باعث مرگ بافت های گیاهی و خشک شدن برگ ها یا ساقه ها شود.
عوامل ایجادکننده بیماری آنتراکنوز
بیماری آنتراکنوز به وسیله چندین گونه قارچی مختلف از جنس Colletotrichum و دیگر قارچ های مشابه ایجاد می شود. این قارچ ها در محیط های مرطوب و گرم رشد کرده و بهترین شرایط برای توسعه بیماری فراهم میشود. عوامل اصلی که باعث گسترش این بیماری میشوند عبارتند از:
-
رطوبت بالا: این قارچ ها به شدت به رطوبت نیاز دارند و در شرایط مرطوب به سرعت تکثیر میشوند.
-
دما: دماهای معتدل و گرم (بین ۲۰ تا ۳۰ درجه سانتی گراد) شرایط مناسبی برای رشد و تکثیر قارچ ها فراهم میآورد.
-
بارندگی و آبیاری زیاد: بارش باران و آبیاری بیش از حد می تواند باعث تجمع رطوبت در برگها و سطح خاک شود و شرایط برای گسترش قارچ ها فراهم شود.
-
نقص در تهویه: اگر گیاهان در شرایطی با تهویه ضعیف قرار بگیرند، رطوبت زیادی در فضا باقی میماند و قارچ ها به راحتی تکثیر میشوند.
انتقال و گسترش بیماری
قارچ های عامل آنتراکنوز معمولاً از طریق اسپورهای خود که در بافتهای آلوده، خاک و برگهای افتاده باقی میمانند، انتقال مییابند. این اسپورها میتوانند از طریق باد، آب یا تماس مستقیم بین گیاهان منتقل شوند. در مواردی، فعالیت های کشاورزی مانند هرس یا برداشت میوه نیز میتواند موجب انتقال قارچها به سایر بخشهای گیاه یا گیاهان دیگر شود.
روش های کنترل بیماری آنتراکنوز
کنترل بیماری آنتراکنوز به دلیل سرعت گسترش و تأثیرات آن بر کیفیت و عملکرد محصولات، نیازمند روش های جامع و مؤثر است. این روشها به دو دسته کلی پیشگیری و درمان تقسیم میشوند:
الف. روشهای پیشگیری:
-
استفاده از ارقام مقاوم: کاشت ارقام مقاوم به آنتراکنوز میتواند از شیوع این بیماری جلوگیری کند.
-
تناوب محصول (Crop Rotation): تغییر گیاهان کشت شده در یک زمین به کاهش میزان قارچ ها کمک میکند.
-
بهبود تهویه: از آنجا که قارچها در شرایط مرطوب به سرعت تکثیر میشوند، ایجاد تهویه مناسب در محیط کشت میتواند از انتشار بیماری جلوگیری کند.
-
مدیریت آبیاری: آبیاری مناسب و کنترل رطوبت میتواند از فراهم آمدن شرایط مناسب برای رشد قارچ ها جلوگیری کند.
-
پاکسازی برگ های آلوده: برگ های آلوده باید از درخت جدا شده و سوزانده شوند تا از انتشار بیماری جلوگیری شود.
روش های درمان
-
استفاده از قارچ کش ها: استفاده از قارچ کش های سیستمیک و تماس برای کنترل و درمان بیماری آنتراکنوز مؤثر است. این قارچ کش ها باید در مراحل ابتدایی شیوع بیماری استفاده شوند.
-
برداشت و حذف میوههای آلوده: میوه های آلوده به بیماری باید به سرعت جمعآوری و از محیط خارج شوند تا از انتشار قارچ جلوگیری شود.
-
محلول پاشی با مواد طبیعی: برخی مواد طبیعی مانند عصاره های گیاهی یا محلول های مسی ممکن است به کنترل قارچ ها کمک کنند.
-
تعویض خاک در گلخانه ها: در صورت کشت در گلخانه ها، تعویض خاک و ضدعفونی آن میتواند از شیوع بیماری جلوگیری کند.
بهترین سموم برای بیماری آنتراکنوز
در مبارزه با بیماری آنتراکنوز، استفاده از قارچ کش های مناسب و با دوز دقیق بسیار مهم است تا هم اثربخشی بالا داشته باشند و هم از بروز مقاومت قارچی جلوگیری شود. در ادامه، بهترین قارچکشهای توصیهشده برای کنترل آنتراکنوز، همراه با طریقه مصرف و دوز پیشنهادی آورده شده است:
بهترین قارچکش ها برای کنترل آنتراکنوز
۱. مانکوزب (Mancozeb)
-
نام تجاری: Dithane M-45، Manzate
-
نوع قارچ کش: تماسی (حفاظتی)
-
دوز مصرف:
-
۲ الی ۲.۵ گرم در لیتر آب
-
-
زمان مصرف: قبل از بروز علائم یا در مراحل اولیه بیماری، هر ۷ تا ۱۰ روز یک بار.
-
نکته مهم: نباید در دوره باردهی سنگین استفاده شود؛ بیشتر جنبه پیشگیری دارد.
۲. کاپتان (Captan)
-
نام تجاری: Merpan، Captan WP
-
نوع قارچ کش: تماسی
-
دوز مصرف:
-
۱.۵ الی ۲ گرم در لیتر آب
-
-
زمان مصرف: در مراحل اولیه آلودگی یا برای محافظت پیش از بارندگی.
۳. آزوکسی استروبین + دیفنوکونازول (Azoxystrobin + Difenoconazole)
-
نام تجاری: Amistar Top
-
نوع قارچ کش: سیستمیک با اثر پیشگیری و درمانی
-
دوز مصرف:
-
۱ الی ۱.۵ میلی لیتر در لیتر آب.
-
-
زمان مصرف: در مراحل ابتدایی بیماری، با تکرار هر ۱۰ تا ۱۴ روز بسته به شدت آلودگی.
-
ویژگی ممتاز: ترکیب دو ماده مؤثر با اثرگذاری بالا و دوره کارنس کوتاه.
۴. کلروتالونیل (Chlorothalonil)
-
نام تجاری: Bravo
-
نوع قارچ کش: تماسی
-
دوز مصرف:
-
۲ الی ۲.۵ میلیلیتر در لیتر آب
-
-
زمان مصرف: مناسب برای پیشگیری و مراحل اولیه آلودگی.
۵. پروپیکونازول (Propiconazole)
-
نام تجاری: Tilt، Bumper
-
نوع قارچ کش: سیستمیک (جذب شونده)
-
دوز مصرف:
-
۰.۵ الی ۱ میلی لیتر در لیتر آب.
-
-
زمان مصرف: در اوایل ظهور علائم بیماری؛ تکرار هر ۱۰ روز یک بار در شرایط بحرانی.
۶. بنومیل
- نام تجاری: Benomyl
- دوز مصرف: یک در هزار
- زمان مصرف: اوایل بهار (قبل از باز شدن کامل برگ ها)، پس از ریزش گل ها و تشکیل میوه
نکات مهم در مصرف قارچ کش ها
-
تناوب استفاده: برای جلوگیری از مقاومت قارچی، از تناوب قارچ کش های مختلف (با مکانیسم اثر متفاوت) استفاده کنید.
-
زمانبندی دقیق: بهترین زمان مصرف، قبل از بارندگی یا در مراحل اولیه آلودگی است.
-
پوشش یکنواخت: محلول پاشی باید به گونه ای باشد که تمام قسمت های گیاه (برگ، ساقه، میوه) کاملاً خیس شوند.
-
استفاده از چسبهای کشاورزی: افزودن چسب های مخصوص (مانند Spreaders) باعث چسبندگی بهتر سم به برگ و افزایش اثر قارچ کش میشود.
-
رعایت دوره کارنس (زمان آخرین سم پاشی تا برداشت): برای میوه ها و محصولات خوراکی بسیار مهم است.
پیشبینی و مدیریت ریسک آنتراکنوز
برای مدیریت مؤثر آنتراکنوز، شبیه سازی شرایط اقلیمی و پیشبینی احتمال وقوع بیماری با استفاده از مدل های پیشبینی بیماری میتواند بسیار مفید باشد. این مدل ها میتوانند اطلاعات دقیقتری درباره زمان دقیق گسترش بیماری و نیاز به استفاده از قارچکش ها فراهم کنند.
آنتراکنوز یکی از بیماری های مهم گیاهی است که می تواند تأثیرات زیادی بر عملکرد و کیفیت محصولات کشاورزی داشته باشد. برای جلوگیری از این بیماری، استفاده از روش های پیشگیرانه، مدیریت مناسب شرایط کشت و استفاده به موقع از قارچکش ها از اهمیت بالایی برخوردار است. با توجه به شرایط اقلیمی و نوع گیاهان، کنترل به موقع این بیماری میتواند به کاهش خسارت ها و افزایش بهره وری کمک کند.